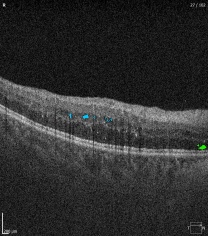

Images
/
N/D
Feature
Subretinal Fluid
Intraretinal Cyst
Retinal Pigment Epithelium Detachment
Subretinal Hyperreflective Material
Epiretinal Membrane
Retinal Drusen
Full Thickness Macular Hole
Lamellar Macular Hole
Vitreomacular Traction
Volumes
Subretinal Fluid
2.183 mm3
Intraretinal Cyst
1.207 mm3
Retinal Pigment Epithelium Detachment
0 mm3
Subretinal Hyperreflective Material
0 mm3
Retinal Drusen
0 mm3
The report is being generated. Please, wait.
100%